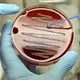
"Đại dịch thầm lặng" khiến thế giới rất khó đối phó

Loại khuẩn gây chết người trong 1 ngày này có thể bùng nổ khi kháng kháng sinh ập đến
Một loại khuẩn tưởng như không nguy hiểm lắm, nhưng giờ đây đang trở thành mối đe dọa rất lớn nếu loài người không tìm ra cách.
Klebsiella pneumoniae là một loại khuẩn có khả năng gây nhiễm trùng, nhưng độ nguy hiểm chỉ ở mức trung bình với con người. Ngay cả trong thời đại kháng thuốc, người ta cũng không tỏ ra quá lo ngại vì K. pneumoniae, vì nó vốn chỉ gây ảnh hưởng đến những người cao tuổi, hoặc đang có hệ miễn dịch yếu thôi.
Tuy nhiên, đây thực chất là một quan niệm sai lầm. Khi phát tác, K. pneumoniae có thể gây ra rất nhiều vấn đề liên quan đến nhiễm trùng, trong đó hiện tượng hoại tử có khả năng giết chết một người khỏe mạnh chỉ trong vòng 1 ngày.

Khuẩn Klebsiella pneumoniae.
Và theo như một nghiên cứu mới đây, K. pneumoniae có một dòng khuẩn rất cần được để ý, vì nhiều khả năng nó sẽ trở thành một cơn ác mộng của thời đại kháng kháng sinh sắp tới.
Khuẩn gì mà kinh khủng quá vậy?
Thông thường, K. pneumoniae chỉ quanh quẩn trong hệ tiêu hóa của con người. Thi thoảng, nó xuất hiện trên da hoặc miệng, và chẳng gây ra chút ảnh hưởng gì. Chỉ những người vốn đã đang có hệ miễn dịch rất yếu mới bị nó hại mà thôi.
Nhưng rồi mọi chuyện bỗng thay đổi vào thập niên 80, khi các bác sĩ tìm ra một dòng khuẩn K. pneumoniae khác hung dữ hơn, nguy hiểm hơn xuất hiện tại Đài Loan. Nó chẳng cần vật chủ phải ốm để lộ diện mà cứ âm ỷ ở đó. Để rồi người bệnh bị phù não, sưng gan, và hoại tử diện rộng.

Tìm ra cách để phân biệt K. Pneumoniae và hvKp là điều cực kỳ quan trọng
Chủng khuẩn ấy được gọi là hypervirulent K. pneumoniae (hvKp). Và đáng chú ý, con người vẫn chưa thể nhận ra dấu hiệu hiện diện của nó. Cho đến thời điểm hiện tại, vẫn chưa rõ các vùng khuẩn K. pneumoniae nào có khả năng chuyển thành hvKp, để đến khi chúng gây tổn hại nghiêm trọng thì đã muộn.
Trước thực tế này, các chuyên gia từ ĐH Buffalo (Mỹ) đã đưa ra đề xuất được cho là khả thi nhất, đó là chế tạo một dạng hóa chất chỉ thị giúp phân biệt hai loại khuẩn này.
Cụ thể, Thomas Russo từ ĐH Buffalo cùng rất nhiều chuyên gia trên thế giới đã tạo ra được chất chỉ thị dành riêng cho hvKp. Nó chỉ phản ứng với ADN của vi khuẩn này, và nhờ thế có độ tin cậy rất cao. Dù vậy, đây vẫn chỉ là bước đầu tiên của cả một quá trình, nhằm tìm ra giải pháp bền vững và lâu dài nhất.
"Hiện tại, không có bất kỳ phương pháp thử nào để phân biệt 2 loại khuẩn" - Russo cho biết.
"Nghiên cứu này cho chúng ta một phương thức rõ ràng, sao cho bất kỳ tổ chức nào cũng có thể tạo ra cách kiểm tra chúng trong phòng thí nghiệm. Nó thực sự rất cần thiết".
Trên thực tế thì cụm từ "cần thiết" vẫn còn là giảm nhẹ. Thực tế cho thấy, các dạng khuẩn kháng thuốc từ K. pneumoniae đã xuất hiện từ vài năm nay, và hậu quả gây ra có thể hết sức nghiêm trọng. Nếu không sớm phân biệt được, ác mộng thực sự sẽ xảy ra nếu hvKp cũng có thể kháng thuốc.

hvKp có thể biến thành khuẩn ăn thịt người, gây hoại tử nghiêm trọng.
Tình hình nghiêm trọng đến mức Tổ chức y tế thế giới WHO đã đặt mục tiêu chế tạo thuốc kháng loại khuẩn này lên mức cần được ưu tiên. Dù hiện tại nó chưa để lại hậu quả đáng chú ý, nhưng con người vẫn đang bị đặt vào tình thế cần cảnh giác.
Theo Russo, việc chỉ cần phân biệt được hvKp thôi cũng đã là bước thành công rất lớn rồi. Dù vậy, các nhà khoa học cần vạch ra một lộ trình rõ ràng, nhằm có được sự chuẩn bị cần thiết khi thời đại kháng thuốc xảy ra.
hvKp có thể trở thành một cơn ác mộng như thế nào?
Có hai con đường để nó xảy ra. Đầu tiên là cả hai dòng khuẩn sẽ cùng xuất hiện, trong đó K. pneumoniae kháng thuốc sẽ thu nhặt và mã hóa lại khả năng ấy, thải nó vào môi trường để hvKp nhận lấy.
Còn cách thứ hai là các loại khuẩn K. pneumoniae bằng cách nào đó hấp thu được khả năng "ăn thịt người" của hvKp. Và trên thực tế, con đường thứ hai này đã xuất hiện rồi.
"Có ít nhất 5 bệnh nhân đã chết tại Hàng Châu, Trung Quốc vì dạng thứ 2" - Russo chia sẻ.
Có rất nhiều điều cần phải tìm hiểu về loại khuẩn này. Tại sao nó xuất hiện nhiều ở châu Á? Đó là nguồn gốc, hay chỉ là do dân số tại đây quá đông? Theo Russo, chúng ta cần thêm nhiều nghiên cứu khác để giải đáp câu hỏi này.
Nghiên cứu được công bố trên tạp chí Clinical Microbiology.
Khám phá
-

Thấy gì từ vụ tên lửa mạnh nhất thế giới nổ giữa không trung
-

WHO kêu gọi tránh xa 3 loại dầu ăn này nếu muốn bảo vệ gan
-

Những điều siêu thú vị về toán học bạn chắc chắn sẽ té ngửa
-

Tru di cửu tộc khiến những người nào bị liên lụy? Tại sao người thân phạm nhân không chạy trốn?
-

Tại sao bầu trời có màu xanh?
-

Tại sao đồng hồ lại được gọi là đồng hồ?
Kháng kháng sinh
-

Chiết xuất từ loại quả này có thể chống lại siêu khuẩn chết người
-

3 loại kháng sinh đánh bại gene kháng thuốc nguy hiểm nhất của siêu vi khuẩn
-

Vi khuẩn kháng kháng sinh tiềm ẩn trong thực phẩm
-

Khi nào bạn cần dùng tới thuốc kháng sinh và khi nào không?
-

Vi khuẩn kháng tất cả các loại thuốc được phát hiện tại Mỹ
-

Thịt lợn Trung Quốc là nguyên nhân khiến nhiều người chết vì nhờn thuốc kháng sinh